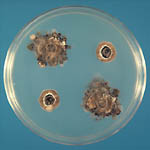

Brown rot of stone fruits
Monilinia fructicola, M. laxa, M. fructigena, M. polystroma, M. mumecola and M. yunnanensis
Stone fruits (peach, nectarine, cherry, plum), almond, and occasionally some pome fruits (apple and pear)
Video of Disease Cycle
Worldwide, brown rot is the most important disease risk for stone fruits in warm, humid climates. It is the primary disease for which fungicides are applied to stone fruits.

Peach fruit rot caused by
Monilinia fructicola and sporulation of the pathogen.
(Photos produced as part of the APS R.J. Tarleton fellowship by M. Dowling, www.phytographics.com, unless otherwise specified)
Symptoms and Signs
Brown rot fungi cause a blight of blossoms and twigs (Figure 2) and a soft decay of peaches (Figure 3), cherries, and plums. Thus, there are two distinct phases of this disease.
 Figure 2 |
 Figure 3 |
 Figure 4 |
 Figure 5 |
 Figure 6 |
 Figure 7 |
Blossom and twig blight
This phase of the disease occurs in early spring when the trees are blooming (Figures 6 & 7), although twig blight also can occur during the fruit rot phase. The anthers and pistil of the flower are infected initially (Figure 8). The fungus then invades the floral tube (Figure 9), the ovary, peduncle, and usually the twig to which the peduncle is attached (Figure 10). Infected blossoms wilt, turn brown, and usually cling to the twig. Extension of the infection into the peduncle and twig results in a necrotic area in the woody tissue termed a "canker" (Figure 10). Sometimes succulent twigs and shoots become infected directly when there are extended periods of both moisture and warm temperatures (20 to 28ºC, 68 to 82ºF).
 Figure 8 |
 Figure 9 |
 Figure 10 |
Under moist or humid conditions, ash-gray-brown colored sporodochia (tufts of conidiophores) bearing conidia (asexual spores) form on the surface of diseased blossoms and twigs (Figure 10). The presence of conidia is a diagnostic sign that separates brown rot from other fungal and bacterial diseases of stone fruits. A gummy substance usually exudes from the cankers, causing the blighted flowers to adhere to the twig.
Fruit rot
Fruit susceptibility to brown rot increases during the 2 to 3 week period prior to harvest. Increased susceptibility is associated with an increase in sugar content as the fruits ripen. Initially, tan-brown, circular spots are visible on the fruit (Figure 11). Under humid conditions, ash-gray-brown masses of conidia develop on these lesions. There can be thousands of conidia on a lesion, each potentially capable of initiating a new infection. If environmental conditions are wet and warm during fruit ripening, the entire crop can literally be destroyed"overnight" (Figure 12).
 Figure 11 |
 Figure 12 |
Diseased fruit that do not fall to the ground dehydrate and become shriveled "mummies" that cling to the branch (Figure 13). Sometimes the fungal infection extends from the fruit into the twig and branch (Figure 14). Although not common, brown rot also can occur on ripe apples and pears.
 Figure 13 |
 Figure 14 |
Pathogen Biology
Monilinia fructicola, M. laxa, and
M. fructigena
The first published description of a brown rot fungus on decaying fruit was in 1796. Different species of brown rot fungi were later discovered. The fruit-rotting fungi were placed in the genus
Sclerotinia in the late 1800s and were transferred to the new genus
Monilinia in 1928.
Of the three closely related fungal species causing brown rot,
M. fructicola is the species most commonly found in North America, Australia, New Zealand, Japan, Brazil and other South American countries.
Monilinia laxa is found in all major fruit producing countries where brown rot occurs.
Monilinia laxa is relatively widespread in California and also occurs in the midwestern and northeastern states, but has not been found in the southeastern states. This species is especially common in Europe, South Africa, and Chile. The disease it causes is frequently called "European brown rot."
Monilinia fructigena occurs on both stone and pome fruits in Europe, but does not cause the extensive crop loss caused by
M. laxa and
M. fructicola. The mycelial growth characteristics of the three
Monilinia species vary when they are grown on 2% potato-dextrose agar (PDA) medium (Figure 15). Isolates of
M. fructicola can have different fruit rotting and sporulation capabilities (Figure 16).
 Figure 15 |
 Figure 16 |
 Figure 1 |
 Figure 10 |
Asexual reproduction
Conidia (asexual spores) are produced on tufts of conidiophores called sporodochia (figures 1 and 10). The conidia are hyaline (colorless), lemon-shaped, and produced in a moniloid manner (resembling a string of beads with constricted ends) (figures 17 and 18). Under ideal conditions, conidia germinate within 3 to 5 hours (Figure 18). Extensive mycelial growth can occur within 24 hours (Figure 19).
 Figure 17 |
 Figure 18 |
 Figure 19 |
Sexual reproduction
Brown rot fungi are ascomycetes. They produce ascospores (sexual spores) in tubular sacs termed asci that are produced on the upper surface of a cup- or disc-shaped structure, known as an apothecium. (figures 20 and 21). Apothecia can be 5-20 mm (up to nearly an inch) in diameter and are borne on mummified fruit that have fallen to the ground. Although commonly described in textbooks, apothecia are rarely observed in most areas.
 Figure 20 |
 Figure 21 |
Disease Cycle and Epidemiology
Disease Cycle
Epidemiology
The opening blossoms are the first emerging susceptible tissue in the spring (Figures 6 and 7). Sources of blossom blight inoculum are mummies (Figure 22), infected peduncles, and cankers. Conidia from these sources are disseminated by splashing or wind-blown rain.
 Figure 6 |
 Figure 7 |
 Figure 22 |
Infrequently, apothecia (Figure 20) develop from mummies on the orchard floor or beneath secondary hosts such as wild plums and other
Prunus spp. surrounding the orchard. Ascospores are released during rainfall and are carried by wind to the blossoms (Figure 23).
 Figure 20 |
 Figure 23 |
Blossom infection is highly dependent on wetness duration and temperature. For blossom infection to occur at 10ºC (50º F), 18 hours of wetting are necessary; in contrast, at 24ºC (77º F) only 5 hours are necessary. The time required for symptoms of blossom blight to develop may be only a few days to 1 or 2 weeks depending on the temperature. Blighted blossoms often are obscured as new flushes of leaf growth occur. Thus, the first evidence that infection has occurred may be yellow and wilting leaves on branches or twigs (Figure 24). It takes very few blighted blossoms (Figure 25) to cause severe fruit rot if environmental conditions are optimal as fruit ripen.
 Figure 24 |
 Figure 25 |
As fruit ripen and the sugar content increases, they become increasingly susceptible to infection. In contrast, green, immature fruit are less prone to infection unless they are injured (Figure 26). Inoculum sources for fruit infection include blighted blossoms, cankers, mummies from the previous year, and diseased fruit in the tree or on the orchard floor from thinning practices. The amount of inoculum is very important in determining the severity of brown rot. Warm, wet or humid weather during the 2 to 3 week period prior to harvest increases disease severity because it increases both the level of inoculum and the amount of infection. If wet weather extends into the harvest period, fruit loss can be severe (Figures 12 and 27). Insects, such as June beetles, which are attracted to overripe fruit, can increase disease severity not only by carrying the fungal conidia but also by creating wounds as they feed. Wet, warm conditions also increase overwintering inoculum available for blossom infections the following spring.
 Figure 26 |
 Figure 12 |
 Figure 27 |
Disease Management
Orchard location is important. Trees planted in orchards having poor air movement, and thus slow drying conditions, are more likely to have blossom blight and brown rot. Successful management of blossom blight and brown rot involves a combination of sanitary practices to reduce the amount of initial inoculum and the judicious use of fungicides. When compared to the results of good sanitation and cultural practices, biological control has had minimal success in the orchard. Biological control has shown better potential for prevention of post-harvest fruit decay.
Sanitation practices
The removal of diseased fruit mummies and blighted twigs from the trees and removal of fruit and mummies from the orchard floor following the final harvest can substantially reduce sources for overwintering inoculum. The orchard floor can be kept clean of vegetation, or the area can be raked or lightly cultivated to bury mummies and prevent the development of apothecia. However, care must be used not to cultivate too deeply to avoid damaging tree roots. If practical, wild Prunus spp. adjacent to the orchard should be removed.
Fungicides
Blossom blight occurrence is very much dictated by the weather conditions. In areas where blossom infection occurs, 1 to 3 fungicide sprays beginning just as the blossoms open (Figure 7) control blossom blight
 Figure 7 |
 Figure 28 |
For brown rot control, 2 to 3 fungicide sprays are usually applied during the 2 to 3 week period leading up to harvest. When combined with good cultural practices, currently registered fungicides are highly effective (Figure 28). In addition, insect control, especially for insects that directly damage fruit, is important during this period.
Disease Risk Analysis and Decision Support Systems
In an effort to more judiciously use fungicides to manage this disease, risk analysis and support systems for decision-making have been developed. These link temperature and moisture conditions, inoculum potential, potential for latent infections and tree growth stages such as bloom and fruit ripening. Such risk analysis systems may provide a risk predication for anticipated disease severity and aid in making decisions as to the need for fungicide sprays.
Post-harvest control
Practices used during harvest can significantly impact the amount of fruit decay following harvest. Picking and handling fruit carefully to avoid injuries, cooling fruit promptly after harvest by hydrocooling or forced air cooling, using clean containers to hold the fruit, and timely harvesting of ripening fruit all help reduce post-harvest brown rot problems.
Fungicides are commonly used to reduce post-harvest fruit decay, but there has been considerable research on alternative control methods. Antagonistic isolates of Bacillus and Pseudomonas spp. have been used experimentally as biological control agents. Substances that induce fruit resistance, such as calcium treatments applied to fruit several weeks before harvest, or surface coatings that provide a physical barrier have also been evaluated in experiments, but are not yet used on a commercial scale.
Significance
Worldwide, brown rot poses the greatest disease risk for crop loss where stone fruits are grown in warm, wet climates. The disease has been studied for almost 200 years in Europe, for more than a 100 years in North America, and in other parts of the world as the fruit industries developed. Until the discovery and development of highly effective fungicides during the last quarter to half-century, significant losses from brown rot could be expected when fruit ripening coincided with periods of rainfall.
|
|
Figure 29 |
The use of fungicides, however, has not been without its problems. When highly effective and specific fungicides were used, brown rot fungi became resistant to them (Figure 29). The brown rot fungi have been used to study resistance to fungicides, serving as a model for development of strategies for managing or delaying the occurrence of fungicide resistance in plant pathogenic fungi.
Quote from 'As You Like It': Act II, Scene vii (in reference by Byrde and Willetts, 1977)
And so, from hour to hour we ripe and ripe,
And then from hour to hour we rot and rot,
And thereby hangs a tale.
Selected References
Biggs, A.R. and J. Northover. 1988. Influence of temperature and wetness on infection of peach and sweet cherry fruits by
Monilinia fructicola. Phytopathology 78:1352-1356.
Byrde, R.J.W. and H.J. Willetts. 1977. The Brown Rot Fungi of Fruit - Their Biology and Control. Pergamon Press, New York, NY.
Hong, C., B. A. Holtz, D. P. Morgan, and T. J. Michailides. 1997. Significance of thinned fruit as a source of the secondary inoculum of
Monilinia fructicola in California nectarine orchards. Plant Dis. 81:519-524.
Hong, C., T. J. Michailides, and B. A. Holtz. 1998. Effects of wounding, inoculum density, and biological control agents on postharvest brown rot of stone fruits. Plant Dis. 82:1210-1216.
Holtz, B.A., T.J. Michailides, and C.X. Hong. 1998. Development of apothecia from stone fruit infected and stromatized by
Monilinia fructicola in California. Plant Dis. 82:1375-1380.
Luo, Y., D. P. Morgan, and T. J. Michailides. 2001. Risk analysis of brown rot blossom blight of prune caused by
Monilinia fructicola. Phytopathology 91:759-768.
Michailides, T.J., Y. Luo, Z. Ma, and D.P. Morgan 2007. Brown Rot of Dried Plum in California: New Insights on an Old Disease.
http://admin.apsnet.org/publications/apsnetfeatures/Pages/BrownRot.aspx
Ogawa, J.M., E.I. Zehr, and A.R. Biggs. 1995. Brown rot. Pages 7-10 in: Compendium of Stone Fruit Diseases. APS Press, St. Paul, MN.
Zehr, E.I. 1982. Control of brown rot in peach orchards. Plant Dis. 66:1101-1105.